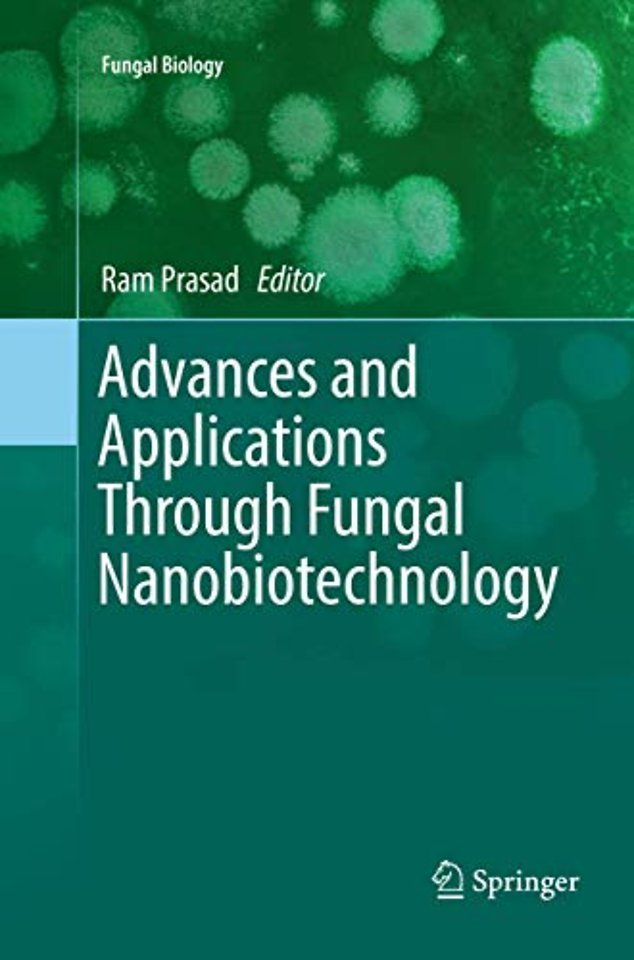
Advances and Applications Through Fungal Nanobiotechnology

Advances and Applications Through Fungal Nanobiotechnology
Samenvatting
Fungal nanobiotechnology has emerged as one of the key technologies, and an eco-friendly, as a source of food and harnessed to ferment and preserve foods and beverages, as well as applications in human health (antibiotics, anti-cholesterol statins, and immunosuppressive agents), while industry has used fungi for large-scale production of enzymes, acids, biosurfactants, and to manage fungal disease in crops and pest control. With the harnessing of nanotechnology, fungi have grown increasingly important by providing a greener alternative to chemically synthesized nanoparticles.